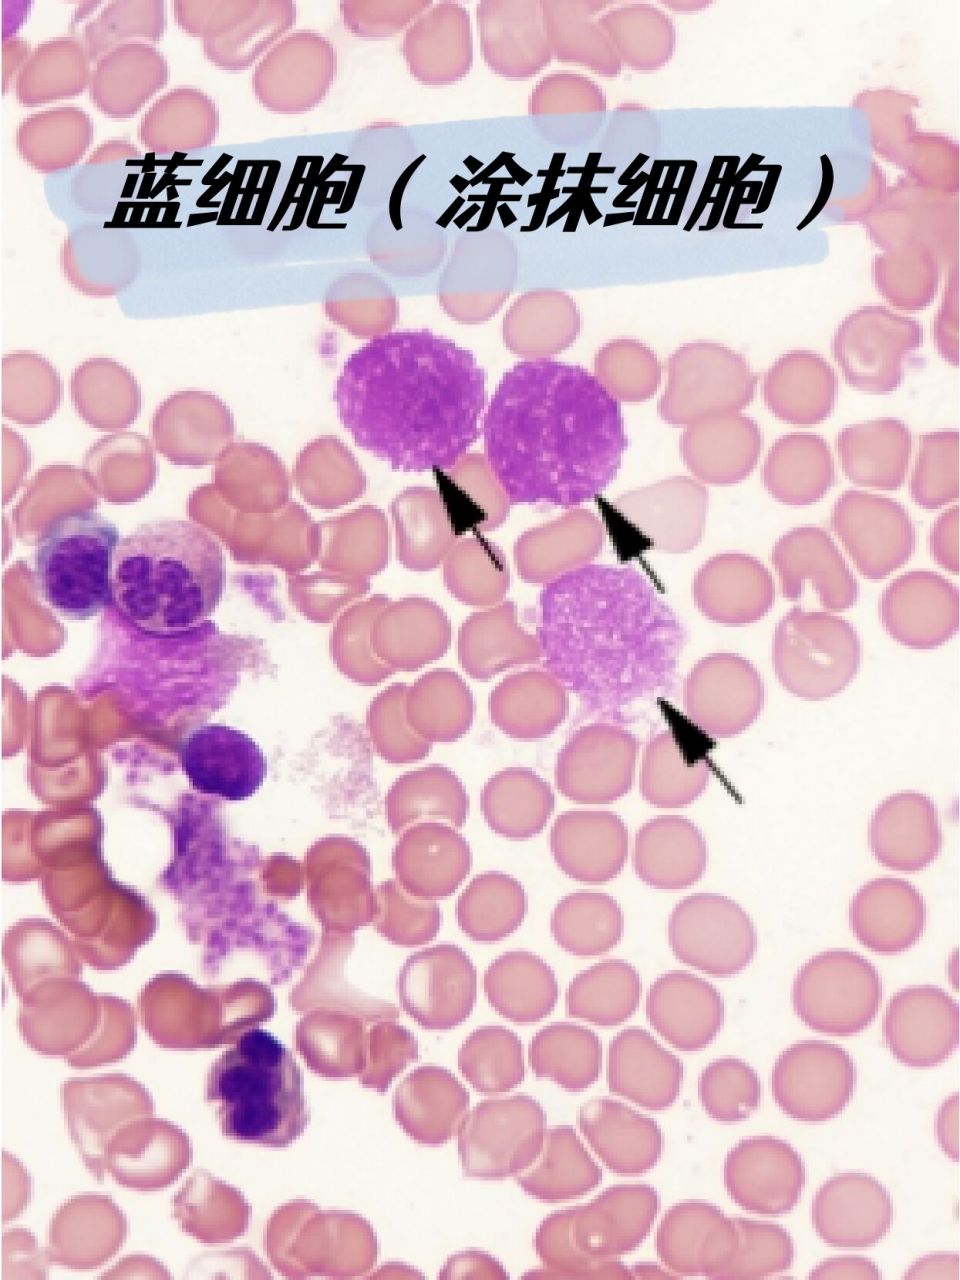
蓝细胞 | 涂抹细胞 | 血细胞形态学检查 9702	 0669♂15

蓝细胞

放大的蓝色细菌细胞
图片尺寸3933x5900
在人教版必修一分子与细胞的教材11页,画着这样一幅蓝细菌细胞模式图
图片尺寸972x641
蓝色背景是人类或动物细胞.
图片尺寸1200x800
显微镜下的蓝色细胞.
图片尺寸1200x720
北京旷博生物技术股份有限公司
图片尺寸1000x1000
蓝细胞显微视图
图片尺寸1100x1100
蓝细胞显微视图
图片尺寸1200x800
人或动物细胞在蓝色背景.
图片尺寸700x467
显微镜下的蓝色细胞
图片尺寸800x608
研究的试剂,仪器和实验室消耗品与实验服务工作,主要从事细胞生物学
图片尺寸474x356
细胞科学显微镜下的蓝色细胞. 生命和生物学,医学科学,分子研究dna.
图片尺寸450x300
蓝细菌细胞,蓝细菌细胞
图片尺寸1024x1024
蓝细胞在路上
图片尺寸1200x1000
蓝色细胞3d立体元素
图片尺寸324x324
显微镜下的蓝色细胞.
图片尺寸1200x720
深蓝色背景上的细胞分裂.
图片尺寸1200x800
这是之前用台盼蓝染色后的图片,请问图中的蓝色的细胞是被染色的死
图片尺寸3264x2448
细胞活力鉴定——台盼蓝染色法 - 蓝色创想 - 蓝色创想
图片尺寸750x559
蓝细胞 | 涂抹细胞 | 血细胞形态学检查 9702 0669♂15
图片尺寸960x1280
这里有从史前时代的环境特征,到地球大爆炸单细胞生命再到多细胞擅
图片尺寸933x1195